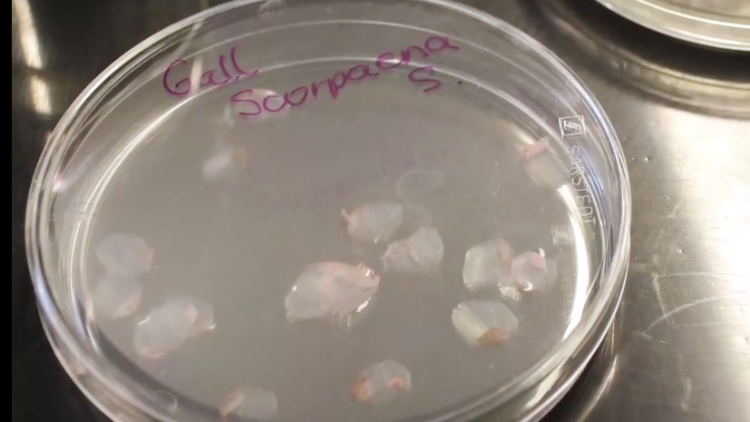
西班牙研究人员利用鱼鳞研发人工角膜 或为角膜患者重见光明带来希望

西班牙格拉纳达大学在3月10日发布的新闻公报中称,其研究人员与同行展开合作,以常见的鱼类鳞片作为原料,成功研发出低成本人工角膜,这为治疗严重角膜疾病提供了全新的潜在解决方案,该成果也有望给眼部疾病治疗带来新的变革。

研究人员在培养皿中处理鱼鳞人工角膜
研究团队对鱼鳞全面分析后发现,其在角膜修复和再生方面具有潜在用途。他们对鲤鱼等市面上常见鱼类的鱼鳞进行处理,制造出具有高度生物相容性、坚韧且透明的角膜植入物,在实验室测试以及动物实验中,其功能效果都表现良好。研究团队中的英格丽·加尔松教授表示:“由于其原料来源广泛,这种产品非常容易获取,而且成本低廉。不仅如此,它还有助于推动当地渔业的发展,可谓一举多得。”

研究人员利用机器切割鱼鳞人工角膜
尽管目前的研究测试表明,这些鱼鳞人工角膜在角膜修复和再生方面具有潜在的应用价值,但距离真正应用于人类临床治疗还有很长的路要走。在进入人体试验阶段之前,还需要进行大量的研究和验证工作。 不过,研究团队也带来了好消息。他们称,这种材料在实验室研究和接受植入物的实验动物身上都取得了良好的功能效果。
培养皿上的鱼鳞
角膜作为眼睛前部透明的表层,对于视力起着至关重要的作用。然而,一旦角膜严重受损,修复难度极大,原因在于它没有血管,自身再生能力也十分有限。目前,严重的角膜疾病通常采用供体移植的方法进行治疗,但这一方式面临着诸多困境,器官供应的短缺以及漫长的等待名单,让许多患者苦不堪言。
据统计,全球约有上千万人因角膜疾病失明,角膜移植是治疗这类疾病的有效方法。由于角膜供体有限,许多需要角膜移植的患者只能在黑暗里等待。专家表示,研发此类人工角膜有助于减少对器官捐献的依赖,为需要接受角膜移植的患者提供低成本替代方案。相关研究论文已发表在国际学术期刊《材料与设计》上。未来,随着研究的不断深入,鱼鳞人工角膜有望成为供体移植的有力替代方案,让更多患者重见光明。
来源|总台环球资讯
编译|王全文
签审|李海霞
监制 | 邹浩宇